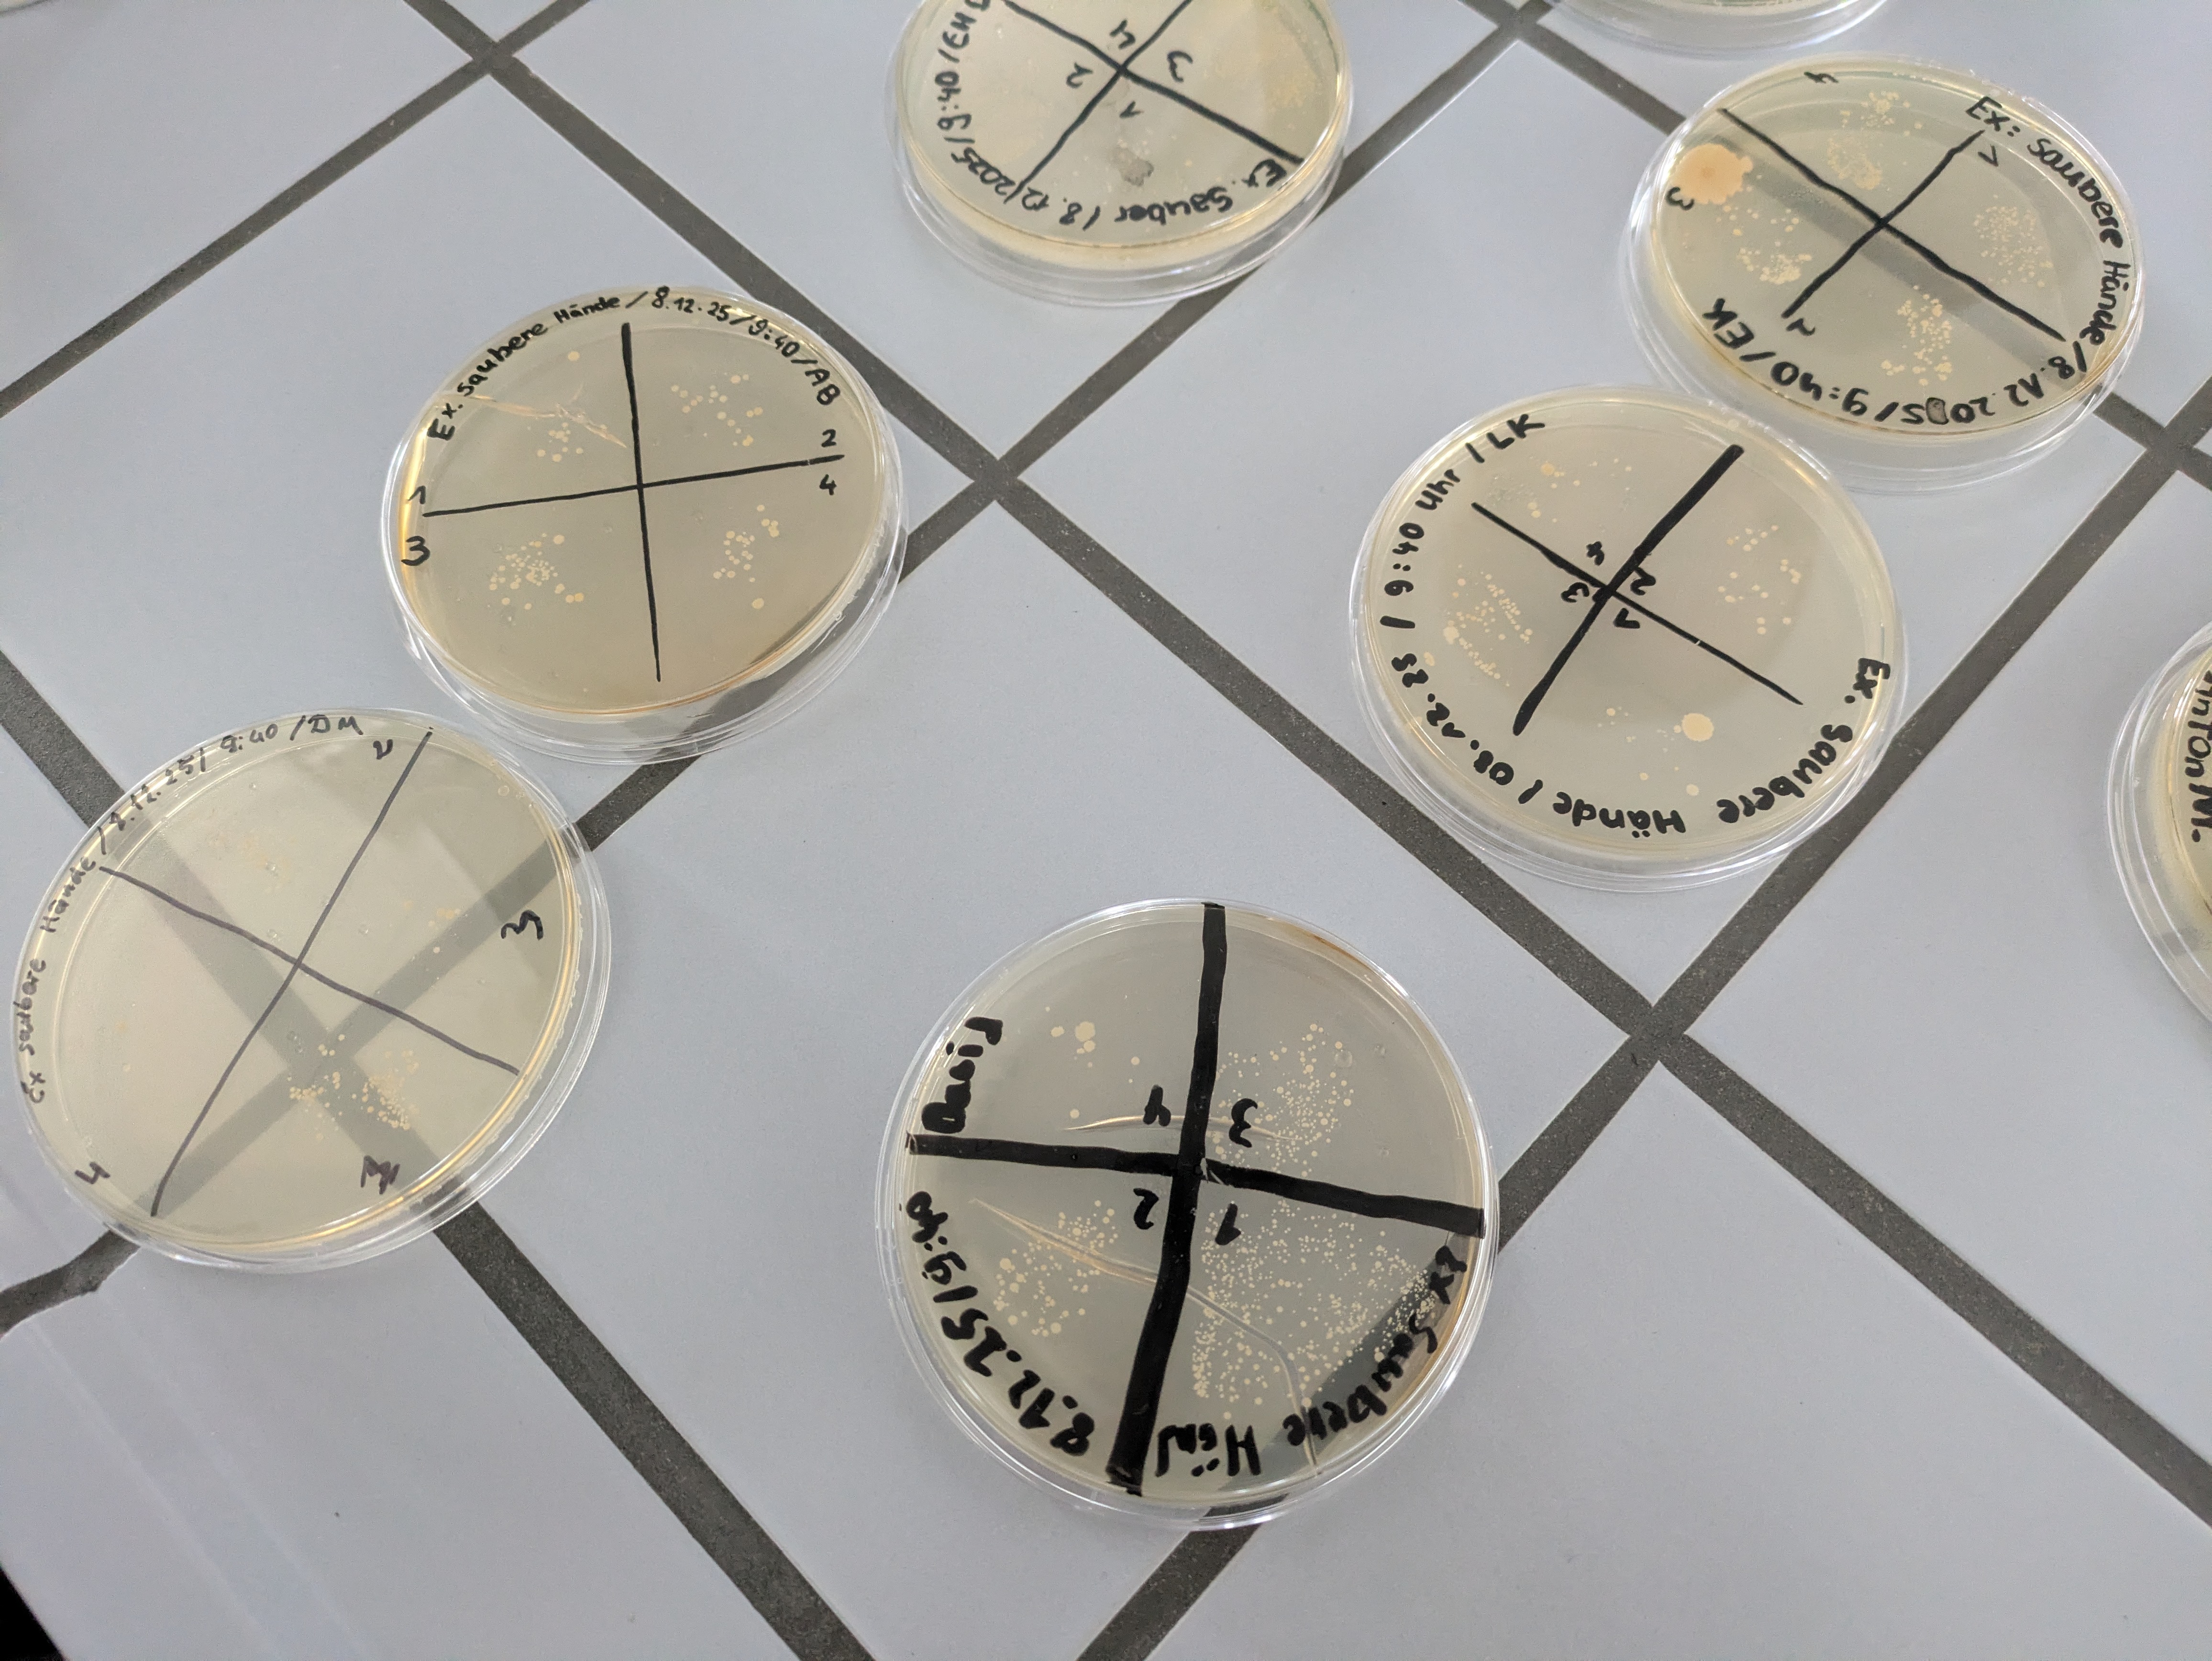

Der naturwissenschaftliche Fachraum
Praktisches Arbeiten im naturwissenschaftlichen Fachraum.
Schülerinnen und Schüler der Klasse 6b führen Experimente in Gruppen durch.


Wintervogelstunde



DNA-Modell



Petrischalen mit Bakterienkulturen


Praktisches Arbeiten im naturwissenschaftlichen Fachraum.
Schülerinnen und Schüler der Klasse 6b führen Experimente in Gruppen durch.